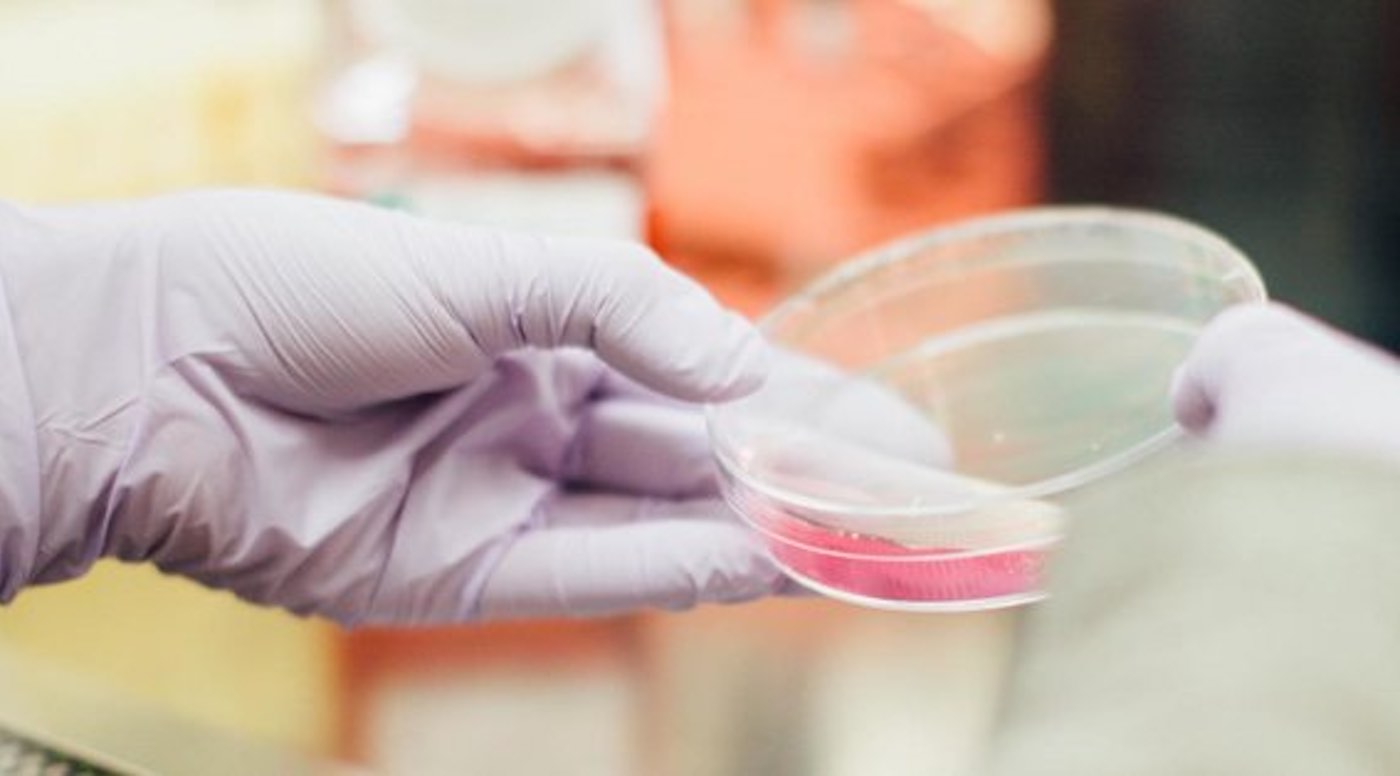

A new technique using patients’ own modified cells to treat Crohn’s disease has proven to be effective in experiments using human cells – and clinical trials of the treatment are expected to start within the next six months.
Researchers developed the technique by studying white blood cells taken from patients who have Crohn’s disease, and comparing them to cells of healthy people. Their findings allowed cell therapy specialists to develop a treatment involving taking patients’ cells, and growing them in a special culture so that they behave more like cells from healthy people.
The research, published in the journal Gastroenterology, shows that this technique is effective in human cells, meaning it is ready for use in a clinical trial. The proposed Tribute Trial will measure whether the treatment is safe and effective for treating Crohn’s.
Crohn’s disease is a lifelong condition in which parts of the digestive system become severely inflamed, causing a range of symptoms such as diarrhea, stomach aches, tiredness, and weight loss. Its causes are unknown, but the immune system is known to play a part. The often debilitating condition is estimated to affect around 620,000 people in the UK alone.
MORE: Boy is Cured of Aggressive Cancer Thanks to Stem Cell Treatment Using Donated Umbilical Cord
The research, which was conducted at the NIHR Guy’s and St Thomas’ Biomedical Research Centre (BRC), was led by Professor Graham Lord, who said: “This is the next frontier in cell therapy, as we’re going beyond treating the symptoms of Crohn’s disease, and trying to reset the immune system to address the condition.
“It’s a real home-grown treatment in the sense that we started with observing cells and tissues donated by patients at Guy’s and St Thomas’, have developed a treatment, and are now starting to undertake trials, all at the Trust. It shows how central patients are to research, helping to create a treatment that might help thousands more people.”
The researchers found that specialized white blood cells called regulatory T cells from Crohn’s patients produced less of a gut-specific protein called integrin α4β7 than regulatory T cells from healthy people. Working with the specialists at the NIHR Guy’s and St Thomas’ BRC’s Advanced Therapies Manufacturing Platform, they developed a cell therapy technique based on these findings.
RELATED: Seven Years After Undergoing Experimental MS Treatment, Woman is Still Experiencing No Symptoms
This technique involves developing cells from the Crohn’s disease patients with a molecule called RAR568, which restores healthy levels of integrin α4β7. The cells are then given back to patients by intravenous infusion.
Dr Peter Irving, a consultant gastroenterologist and co-author on the paper, said: “While the treatments available for Crohn’s disease have increased over recent years, they only work in some patients. In addition, the treatments have potentially serious side effects in some patients. This research paves the way for a trial of using patients’ own cells to treat their Crohn’s disease and we look forward to offering people the chance to take part in the very near future.”
The treatment was recently hailed by 50-year-old Rachel Sawyer, a communications manager from southeast London who was diagnosed with Crohn’s disease in 2000 and treated at Guy’s and St Thomas’. Although her condition is now under control, she supports other people who have Crohn’s and runs an advocacy Twitter account for the disease.
CHECK OUT: Doctor Who Discovered Natural Way to Treat Vertigo for Free Writes Book On How Sufferers Can Thrive
She said: “One of the worst things for me was the unpredictability, particularly around needing the toilet in a hurry. Having Crohn’s completely re-routes your daily life and makes it hard to do the normal things most of us take for granted like going out socially or taking public transport.
“Anything that could help people with Crohn’s have the confidence to go out and get back to being the people they were destined to be would be a game-changer.”
(Source: NIHR Guy’s and St Thomas’ BRC)
Cure Your Friends Of Negativity By Sharing The Good News To Social Media – Photo by NIHR Guy’s and St Thomas’ BRC